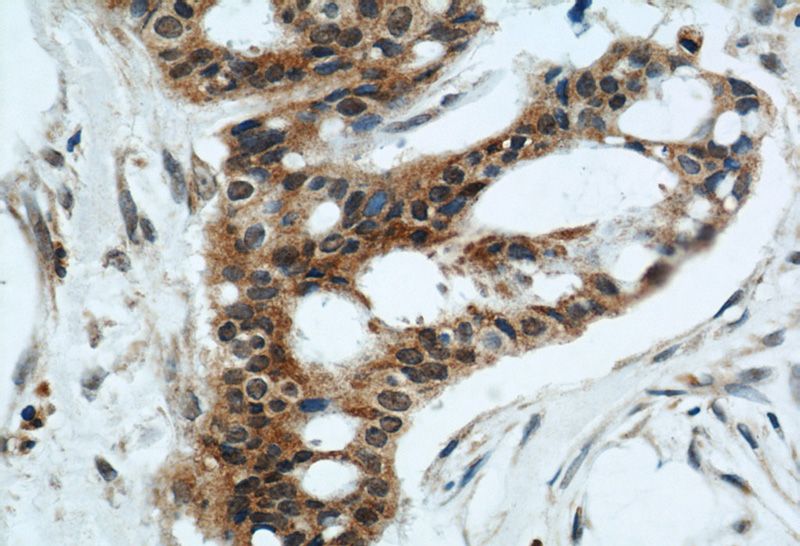
Immunohistochemical of paraffin-embedded human breast cancer using Catalog No:110704(FOXO3A antibody) at dilution of 1:50 (under 40x lens)

-
Product Name
FOXO3A antibody
- Documents
-
Description
FOXO3A Rabbit Polyclonal antibody. Positive WB detected in HEK-293 cells, HeLa cells, PC-3 cells. Positive IF detected in HeLa cells. Positive IHC detected in human breast cancer tissue, human prostate cancer tissue. Observed molecular weight by Western-blot: 72-97 kDa
-
Tested applications
ELISA, WB, IHC, IF
-
Species reactivity
Human,Mouse,Rat; other species not tested.
-
Alternative names
AF6q21 antibody; AF6q21 protein antibody; DKFZp781A0677 antibody; FKHRL1 antibody; FKHRL1P2 antibody; forkhead box O3 antibody; Forkhead box protein O3 antibody; FOXO2 antibody; FOXO3 antibody; FOXO3A antibody
-
Isotype
Rabbit IgG
-
Preparation
This antibody was obtained by immunization of FOXO3A recombinant protein (Accession Number: NM_201559). Purification method: Antigen affinity purified.
-
Clonality
Polyclonal
-
Formulation
PBS with 0.1% sodium azide and 50% glycerol pH 7.3.
-
Storage instructions
Store at -20℃. DO NOT ALIQUOT
-
Applications
Recommended Dilution:
WB: 1:200-1:2000
IHC: 1:20-1:200
IF: 1:10-1:100
-
Validations

HEK-293 cells were subjected to SDS PAGE followed by western blot with Catalog No:110704(FOXO3A antibody) at dilution of 1:500
Immunohistochemical of paraffin-embedded human breast cancer using Catalog No:110704(FOXO3A antibody) at dilution of 1:50 (under 40x lens)

Immunofluorescent analysis of HeLa cells using Catalog No:110704(FOXO3A Antibody) at dilution of 1:25 and Alexa Fluor 488-congugated AffiniPure Goat Anti-Rabbit IgG(H+L)
-
Background
In mammalian cells, FoxO factors act as potent transcriptional activators that upregulate the expression of programs of genes involved in stress resistance, cell cycle arrest, differentiation, apoptosis, autophagy, and metabolism. FOXO3 has a key role in the maintenance of adult neural and hematopoietic stem cells. It also associates with extreme longevity in humans and regulates the homeostasis of adult stem cell pools in mammals, which may contribute to longevity. Phosphorylation inhibits FOXO3 nuclear translocation that is essential for its regulation and function
-
References
- Ji WG, Zhang XD, Sun XD, Wang XQ, Chang BP, Zhang MZ. miRNA-155 modulates the malignant biological characteristics of NK/T-cell lymphoma cells by targeting FOXO3a gene. Journal of Huazhong University of Science and Technology. Medical sciences = Hua zhong ke ji da xue xue bao. Yi xue Ying De wen ban = Huazhong keji daxue xuebao. Yixue Yingdewen ban. 34(6):882-8. 2014.
- Chen Z, Kang X, Wang L. Rictor/mTORC2 pathway in oocytes regulates folliculogenesis, and its inactivation causes premature ovarian failure. The Journal of biological chemistry. 290(10):6387-96. 2015.
- Jia Y, Gao G, Song H, Cai D, Yang X, Zhao R. Low-protein diet fed to crossbred sows during pregnancy and lactation enhances myostatin gene expression through epigenetic regulation in skeletal muscle of weaning piglets. European journal of nutrition. 2015.
Related Products / Services
Please note: All products are "FOR RESEARCH USE ONLY AND ARE NOT INTENDED FOR DIAGNOSTIC OR THERAPEUTIC USE"
